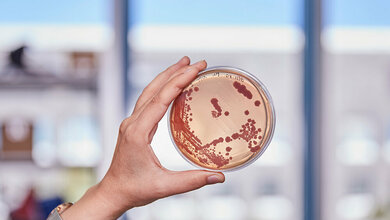
Bakterienkultur

Medizinforschungsgesetz: Gesetzentwurf verabschiedet
Mit dem Medizinforschungsgesetz werden, so das Bundesgesundheitsministerium, „Genehmigungsverfahren für klinische Prüfungen sowie Zulassungsverfahren von Arzneimitteln, Medizinprodukten und forschungsbedingten Strahlenanwendungen beschleunigt und entbürokratisiert, bei gleichzeitiger Wahrung der hohen Standards für die Sicherheit von Patientinnen und Patienten“.
„Mit dem Medizinforschungsgesetz stärken wir die Erforschung und Herstellung neuer Arzneimittel und Medizinprodukte am Standort Deutschland. Wir sorgen für schnelle, verlässliche und unbürokratische Verfahren. Das gibt den beteiligten Forschenden und Unternehmen Planungssicherheit. Es stärkt den Forschungsstandort und fördert Wachstum und Beschäftigung. Und es kommt direkt den Patientinnen und Patientinnen in Deutschland zugute, die von neuen Therapien profitieren können“, erläuterte Bundesgesundheitsminister Karl Lauterbach (SPD) den Gesetzentwurf.
Möglichkeiten der Digitalisierung
Bundesumweltministerin Steffi Lemke (Bündnis 90/Die Grünen) ergänzte: „Wir vereinfachen und beschleunigen die Zulassungsverfahren für forschungsbedingte Strahlenanwendungen, indem wir Doppelprüfungen abbauen und die Möglichkeiten der Digitalisierung nutzen. Dabei bleiben hohe ethische und wissenschaftliche Standards gewahrt und ein wirksamer Strahlenschutz erhalten. So schaffen wir mit dem Medizinforschungsgesetz attraktive Rahmenbedingungen für innovative medizinische Forschung."
Kritik an dem Gesetzentwurf gab es unter anderem von Bundesärztekammerpräsident Klaus Reinhardt. Die geplante Einrichtung einer Bundesethikkommission beim Bundesinstitut für Arzneimittel und Medizinprodukte könnte zur Entstehung von Interessenkonflikten führen und sei deshalb zu vermeiden, befürchtet er in einem Podcast.
„Spielräume für eine intransparente Preisgestaltung"
Stefanie Stoff-Ahnis, Vorständin des GKV-Spitzenverbandes, erklärte: „Wir kritisieren deutlich, dass es in Zukunft geheime und intransparente Erstattungsbeträge bei Arzneimitteln geben soll. Geheimpreise eröffnen den Pharmaunternehmen Spielräume für eine intransparente Preisgestaltung und werden die Kosten nach oben treiben. Dabei reden wir nicht von Millionen, sondern von vielen Milliarden Euro jedes Jahr an Mehrkosten für die Beitragszahlerinnen und Beitragszahler ohne Mehrwert für die Versorgung.“
Der PKV-Verband begrüßt die vorgesehenen Änderungen im Arzneimittelrabattgesetz. Die Regelungen ermöglichten es, die bei Nacherstattungen entstehenden, zu viel entrichteten Zuschläge nach der Arzneimittelpreisverordnung und die zu viel entrichtete Umsatzsteuer rechtssicher geltend zu machen. Die Einführung vertraulicher Erstattungsbeträge stärke hingegen nicht den Standort Deutschland. „Die Maßnahme liefert keinen Beitrag für eine effiziente und nachhaltige Versorgung der Versicherten mit Arzneimitteln und führt zu Mehrausgaben. Verdeckte Rabatte haben hohe bürokratische Aufwände zur Folge.“
Der Präsident des Verbandes Forschender Arzneimittelhersteller, Han Steutel, betonte: „Es ist gut, dass die Bundesregierung nun die Umsetzung ihrer Pharmastrategie angeht, und mit dem Referentenentwurf die Forschung in den Fokus nimmt. Denn klinische Pharmaforschung im eigenen Land ist für die Versorgung von Patientinnen und Patienten sowie den Pharmastandort Deutschland elementar. In diesem Bereich verliert unser Land seit vielen Jahren an Boden. Um hier gegenzusteuern, sind schnellere Entscheidungswege und landesweit konsistente ethische und datenschutzrechtliche Anforderungen nötig. Der Referentenentwurf weist hier in die richtige Richtung, springt aber noch zu kurz, um Deutschland wieder in die internationale Spitzengruppe zurückzubringen.“
Die wichtigsten Maßnahmen im Überblick:
- Die Zusammenarbeit der Arzneimittelzulassungsbehörden wird optimiert.
- Die Bewertung mononationaler klinischer Prüfungen wird beschleunigt.
- Dezentrale klinische Prüfungen außerhalb der Prüfzentren werden ermöglicht.
- Die Kennzeichnung von Prüf- und Hilfspräparaten wird vereinfacht.
- Es werden Standardvertragsklauseln für klinische Prüfungen veröffentlicht.
- Es wird eine unabhängige spezialisierte Ethikkommission für besonders komplexe oder eilige Verfahren eingerichtet.
- Die Ethikkommissionen der Länder spezialisieren sich auf bestimmte Verfahrenstypen.
- Der Arbeitskreis Medizinischer Ethik-Kommissionen erhält eine Richtlinienbefugnis.
- Die Auslegungspraxis der Länder hinsichtlich der Herstellungserlaubnis und Prüfung bestimmter Arzneimittel wird durch Empfehlungen des Bundes harmonisiert.
- Pharmazeutische Unternehmer erhalten die Möglichkeit, vertrauliche Erstattungsbeträge bei neuen Arzneimitteln zu vereinbaren.
- Die strahlenschutzrechtlichen Anzeige- und Genehmigungsverfahren werden mit den arzneimittel- und medizinprodukterechtlichen Verfahren harmonisiert.
- Die Einreichung von strahlenschutzrechtlichen Anträgen und Anzeigen für Forschungsvorhaben, die auch einer arzneimittel- oder medizinprodukterechtlichen Genehmigung oder Anzeige bedürfen, erfolgt künftig über die gleichen Portale (Single-Gate-Ansatz).
- Die strahlenschutzrechtlichen Prüffristen werden verkürzt.
- Nuklearmedizinische Einrichtungen werden von der Erlaubnispflicht bei der Herstellung radioaktiver diagnostischer Prüfpräparate befreit.
Quellen: BMG, BÄK. GKV-Spitzenverband, PKV-Verband, vfa
Artikel teilen